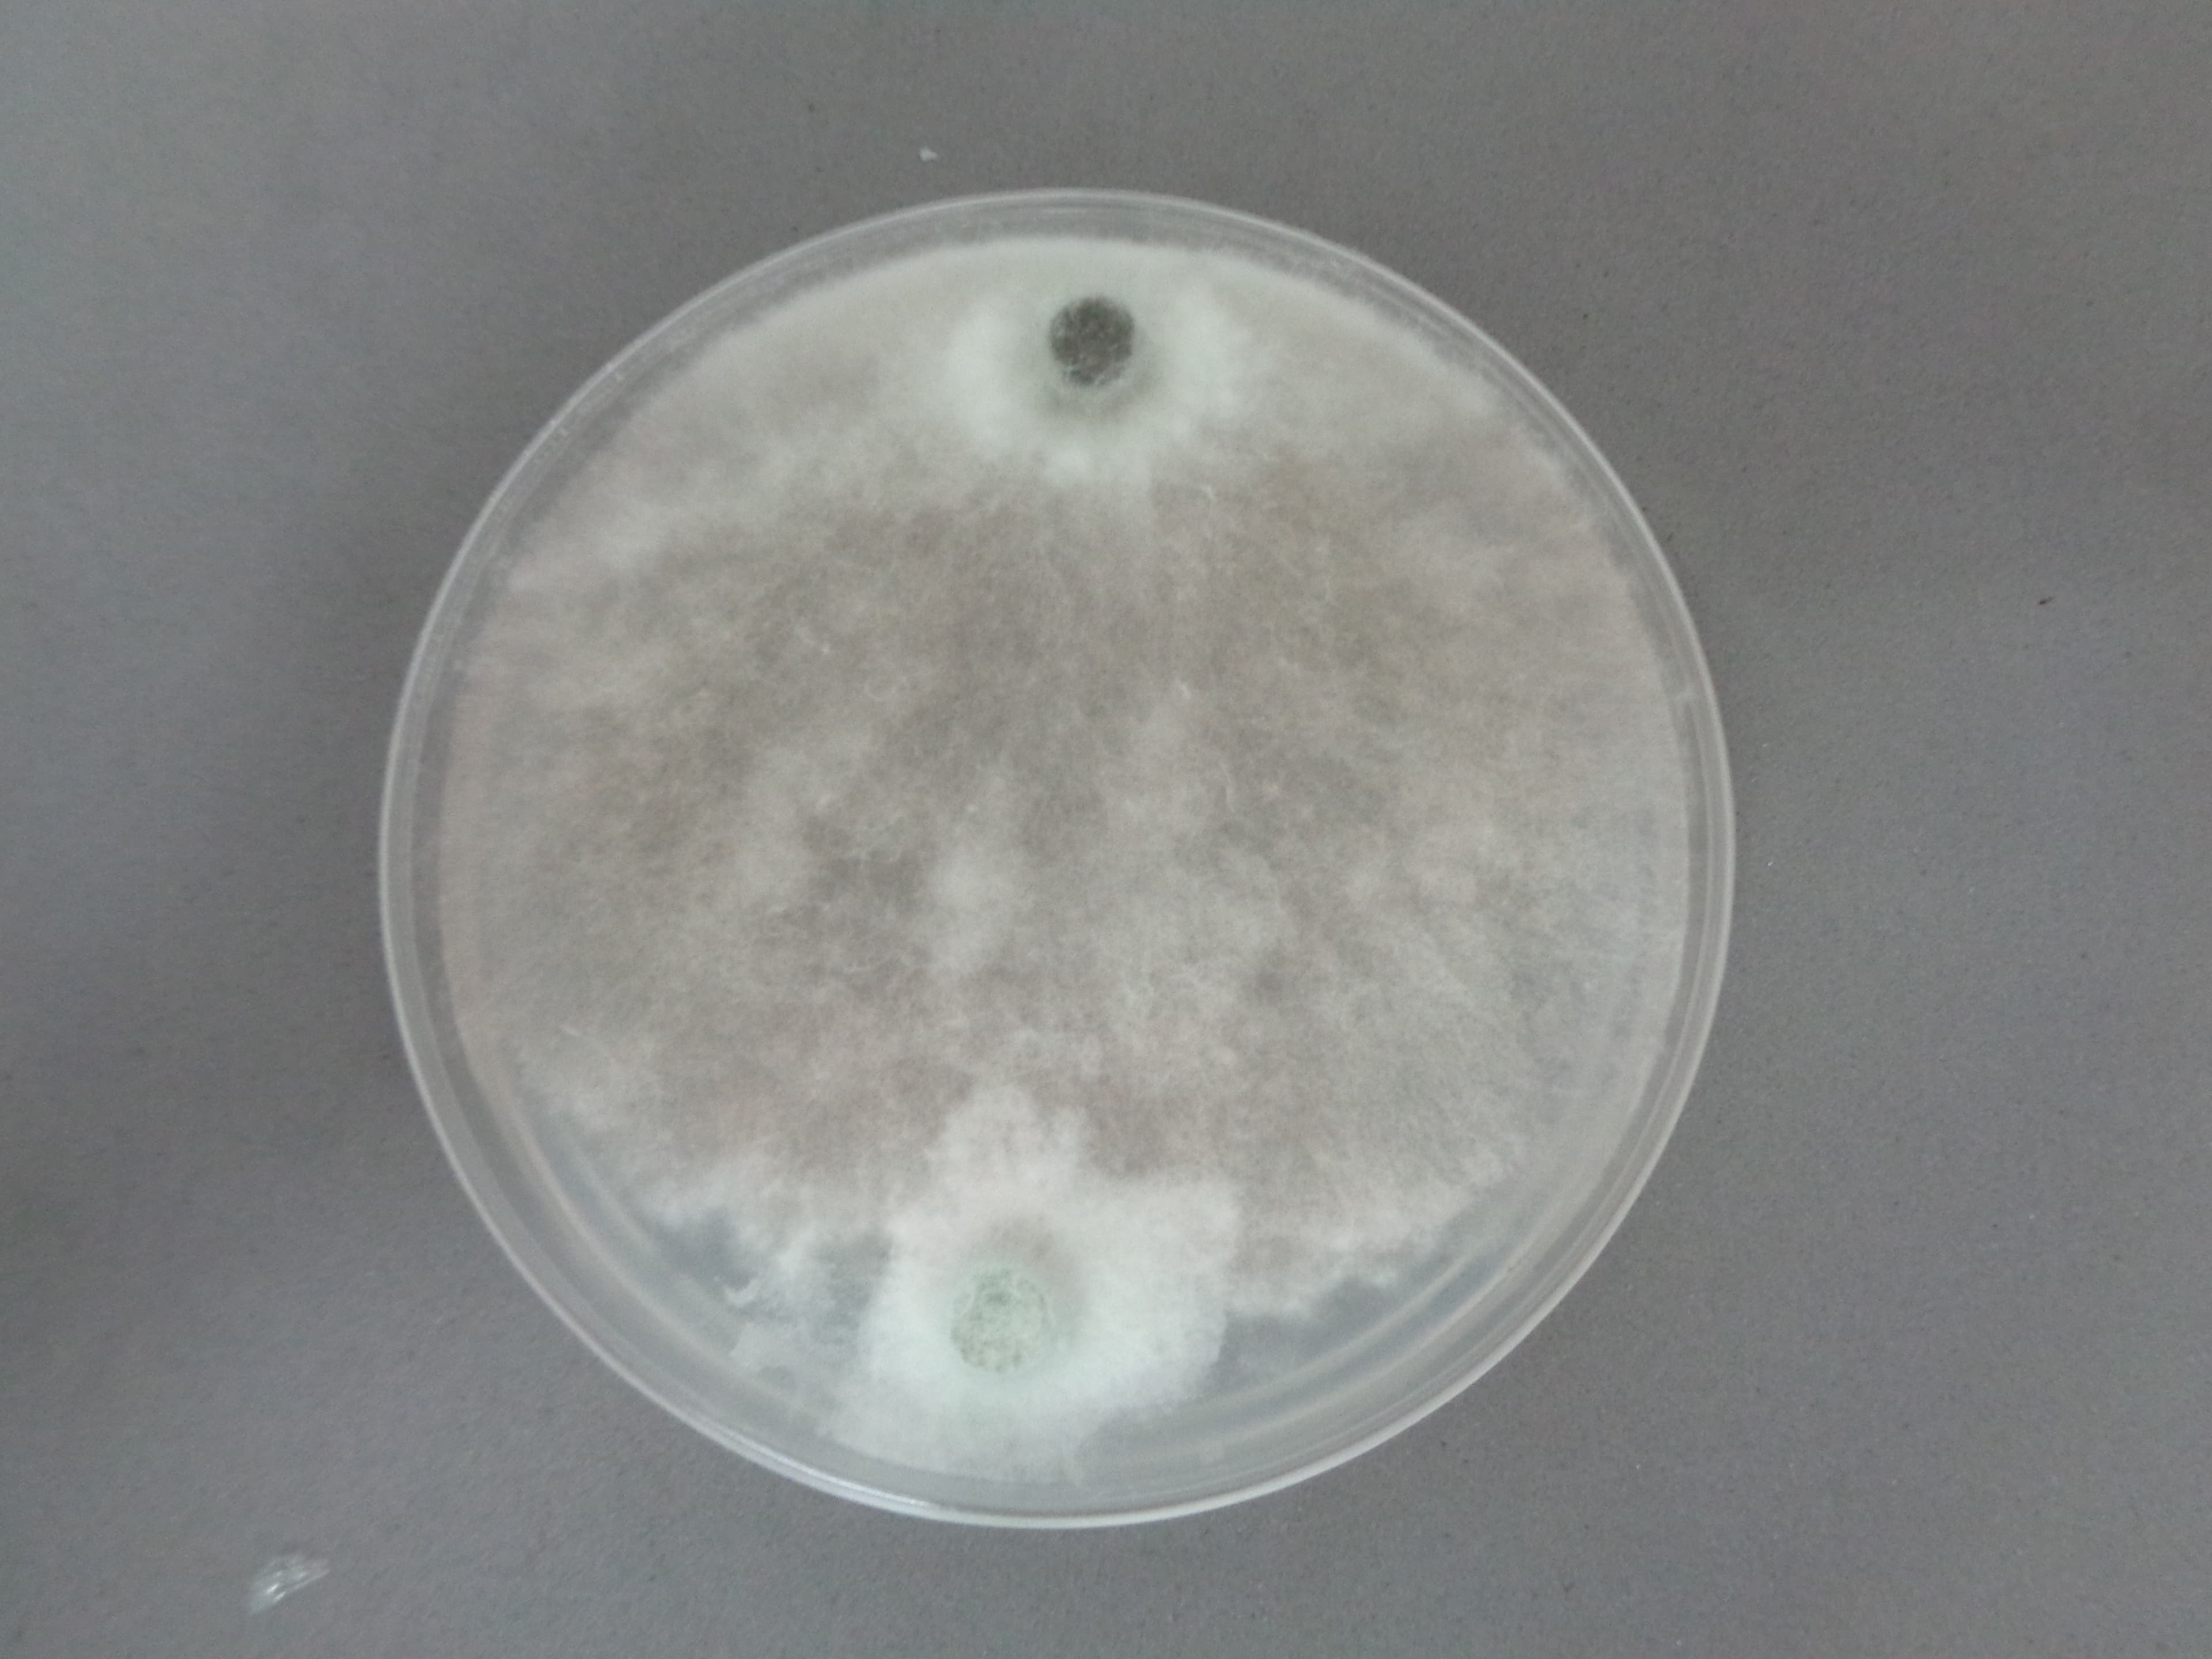
Trichoderma placa completa
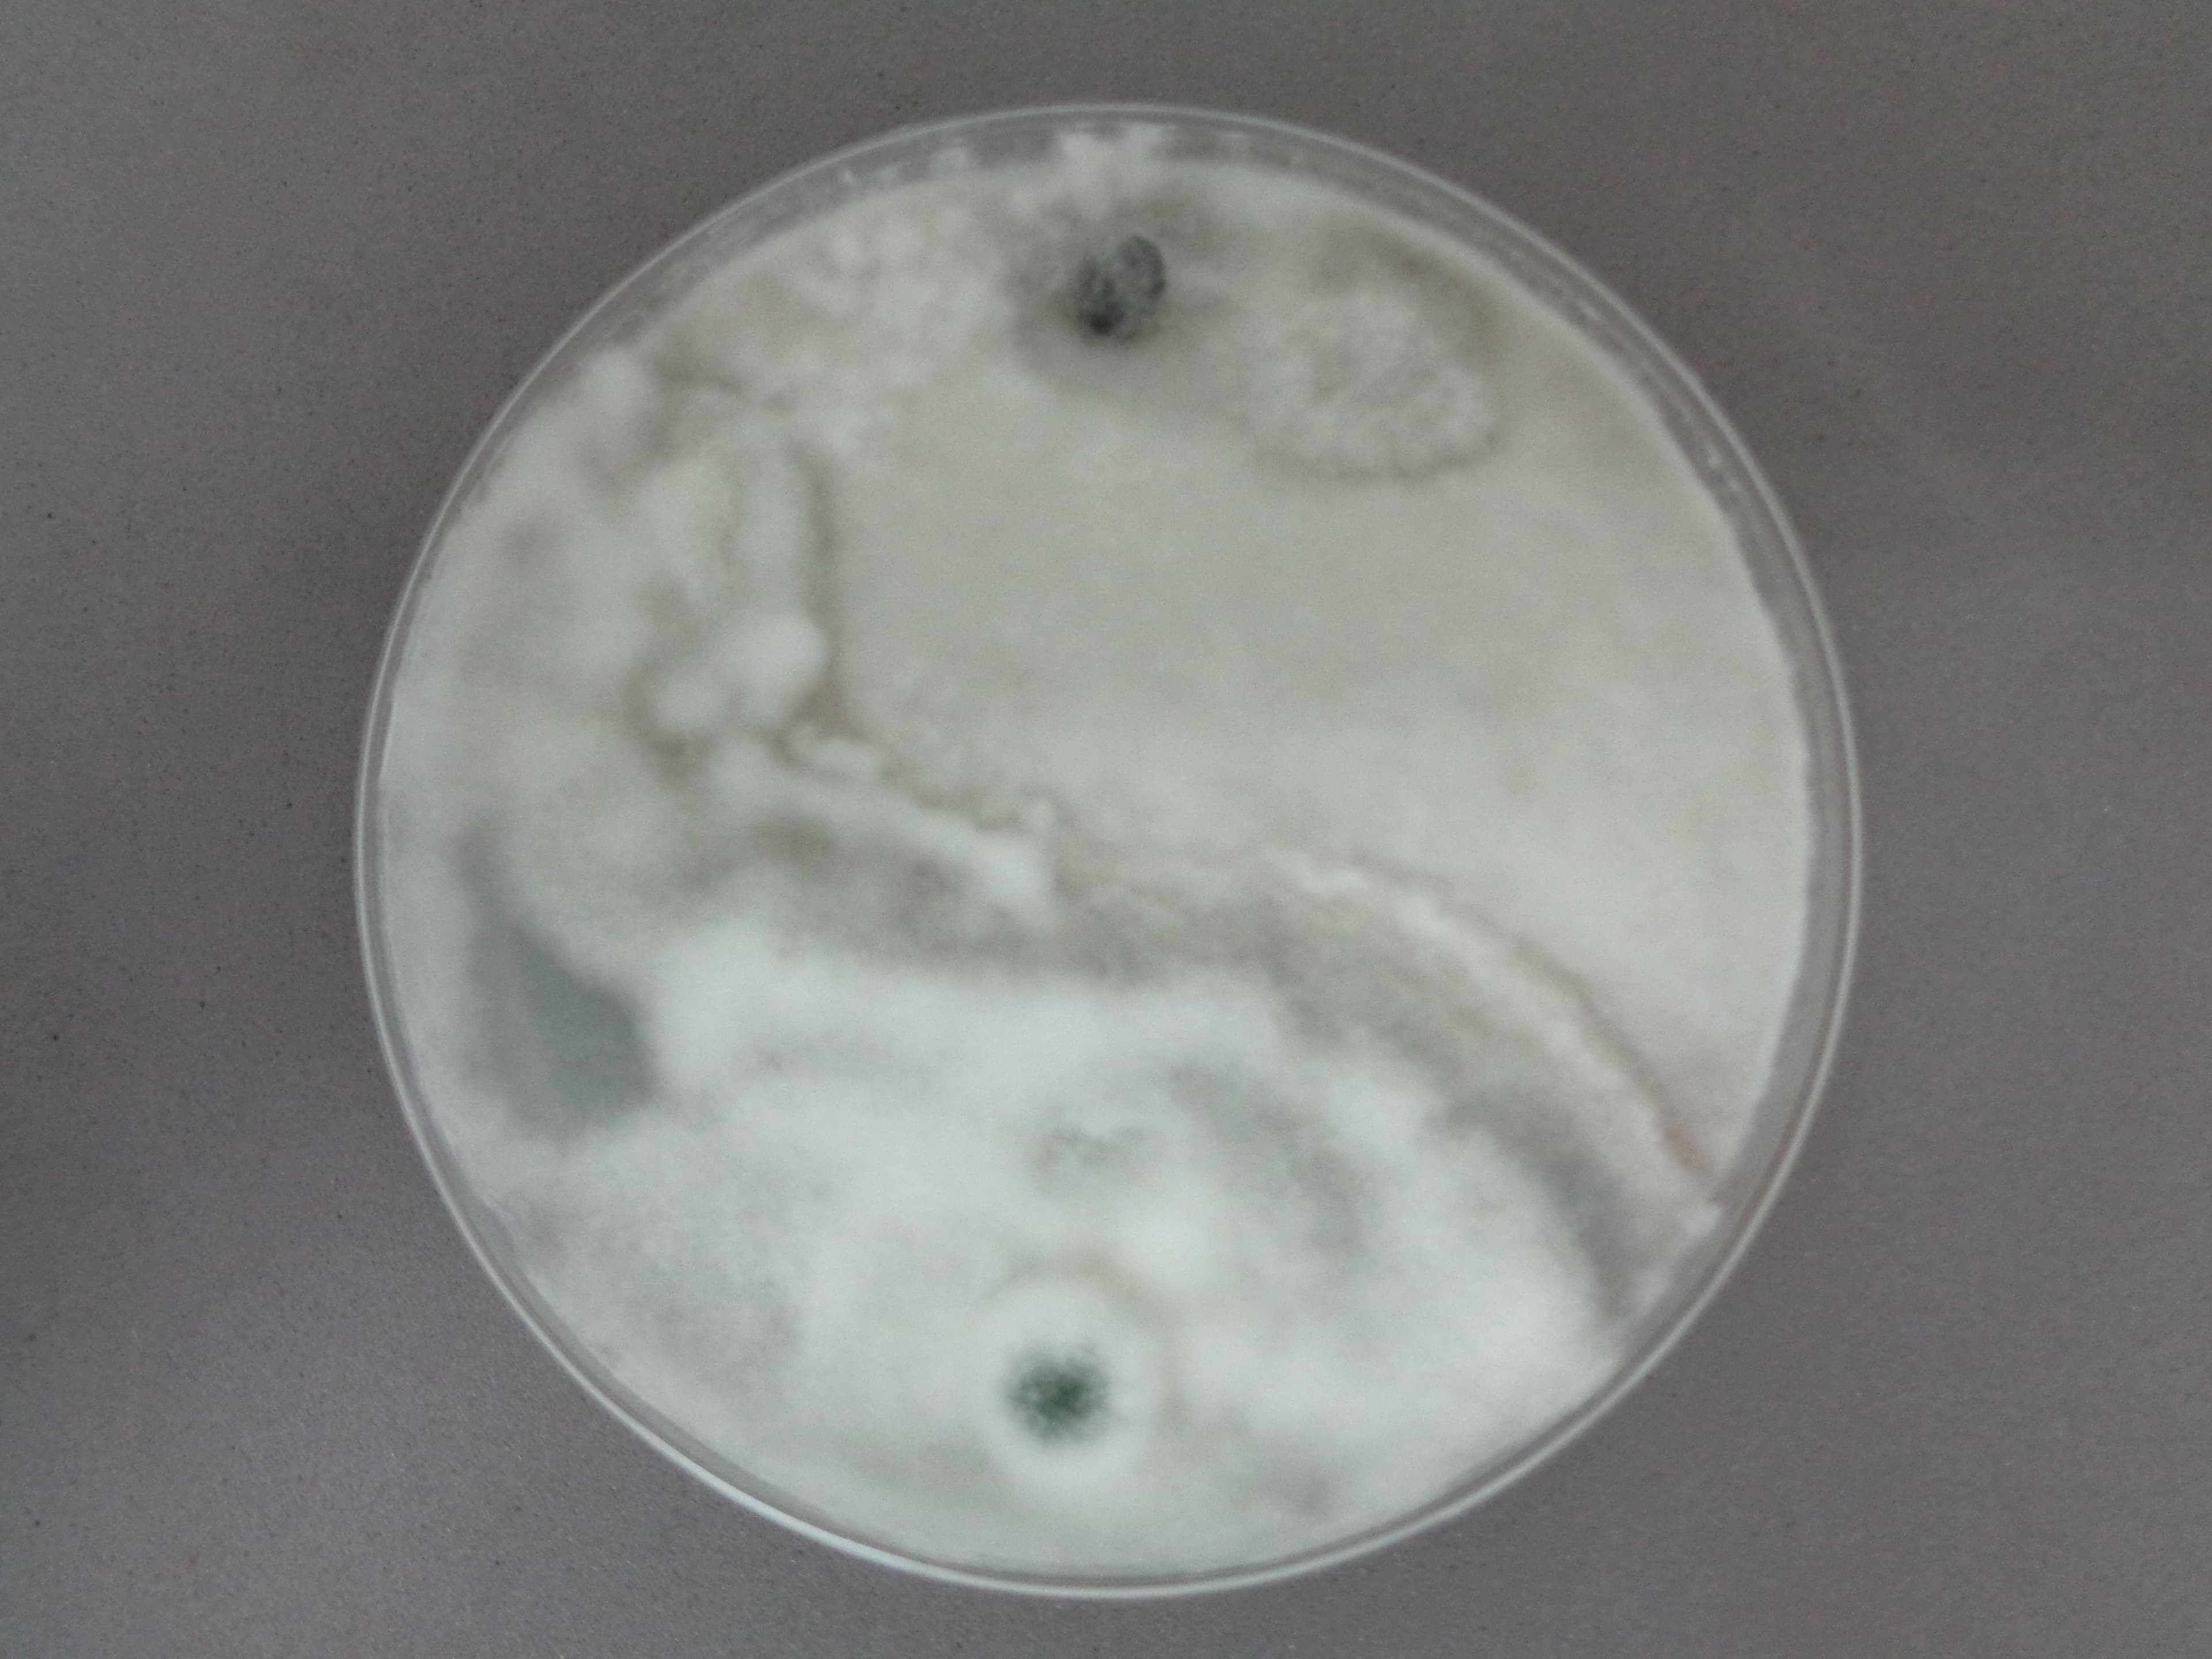
Trichoderma conidioforos
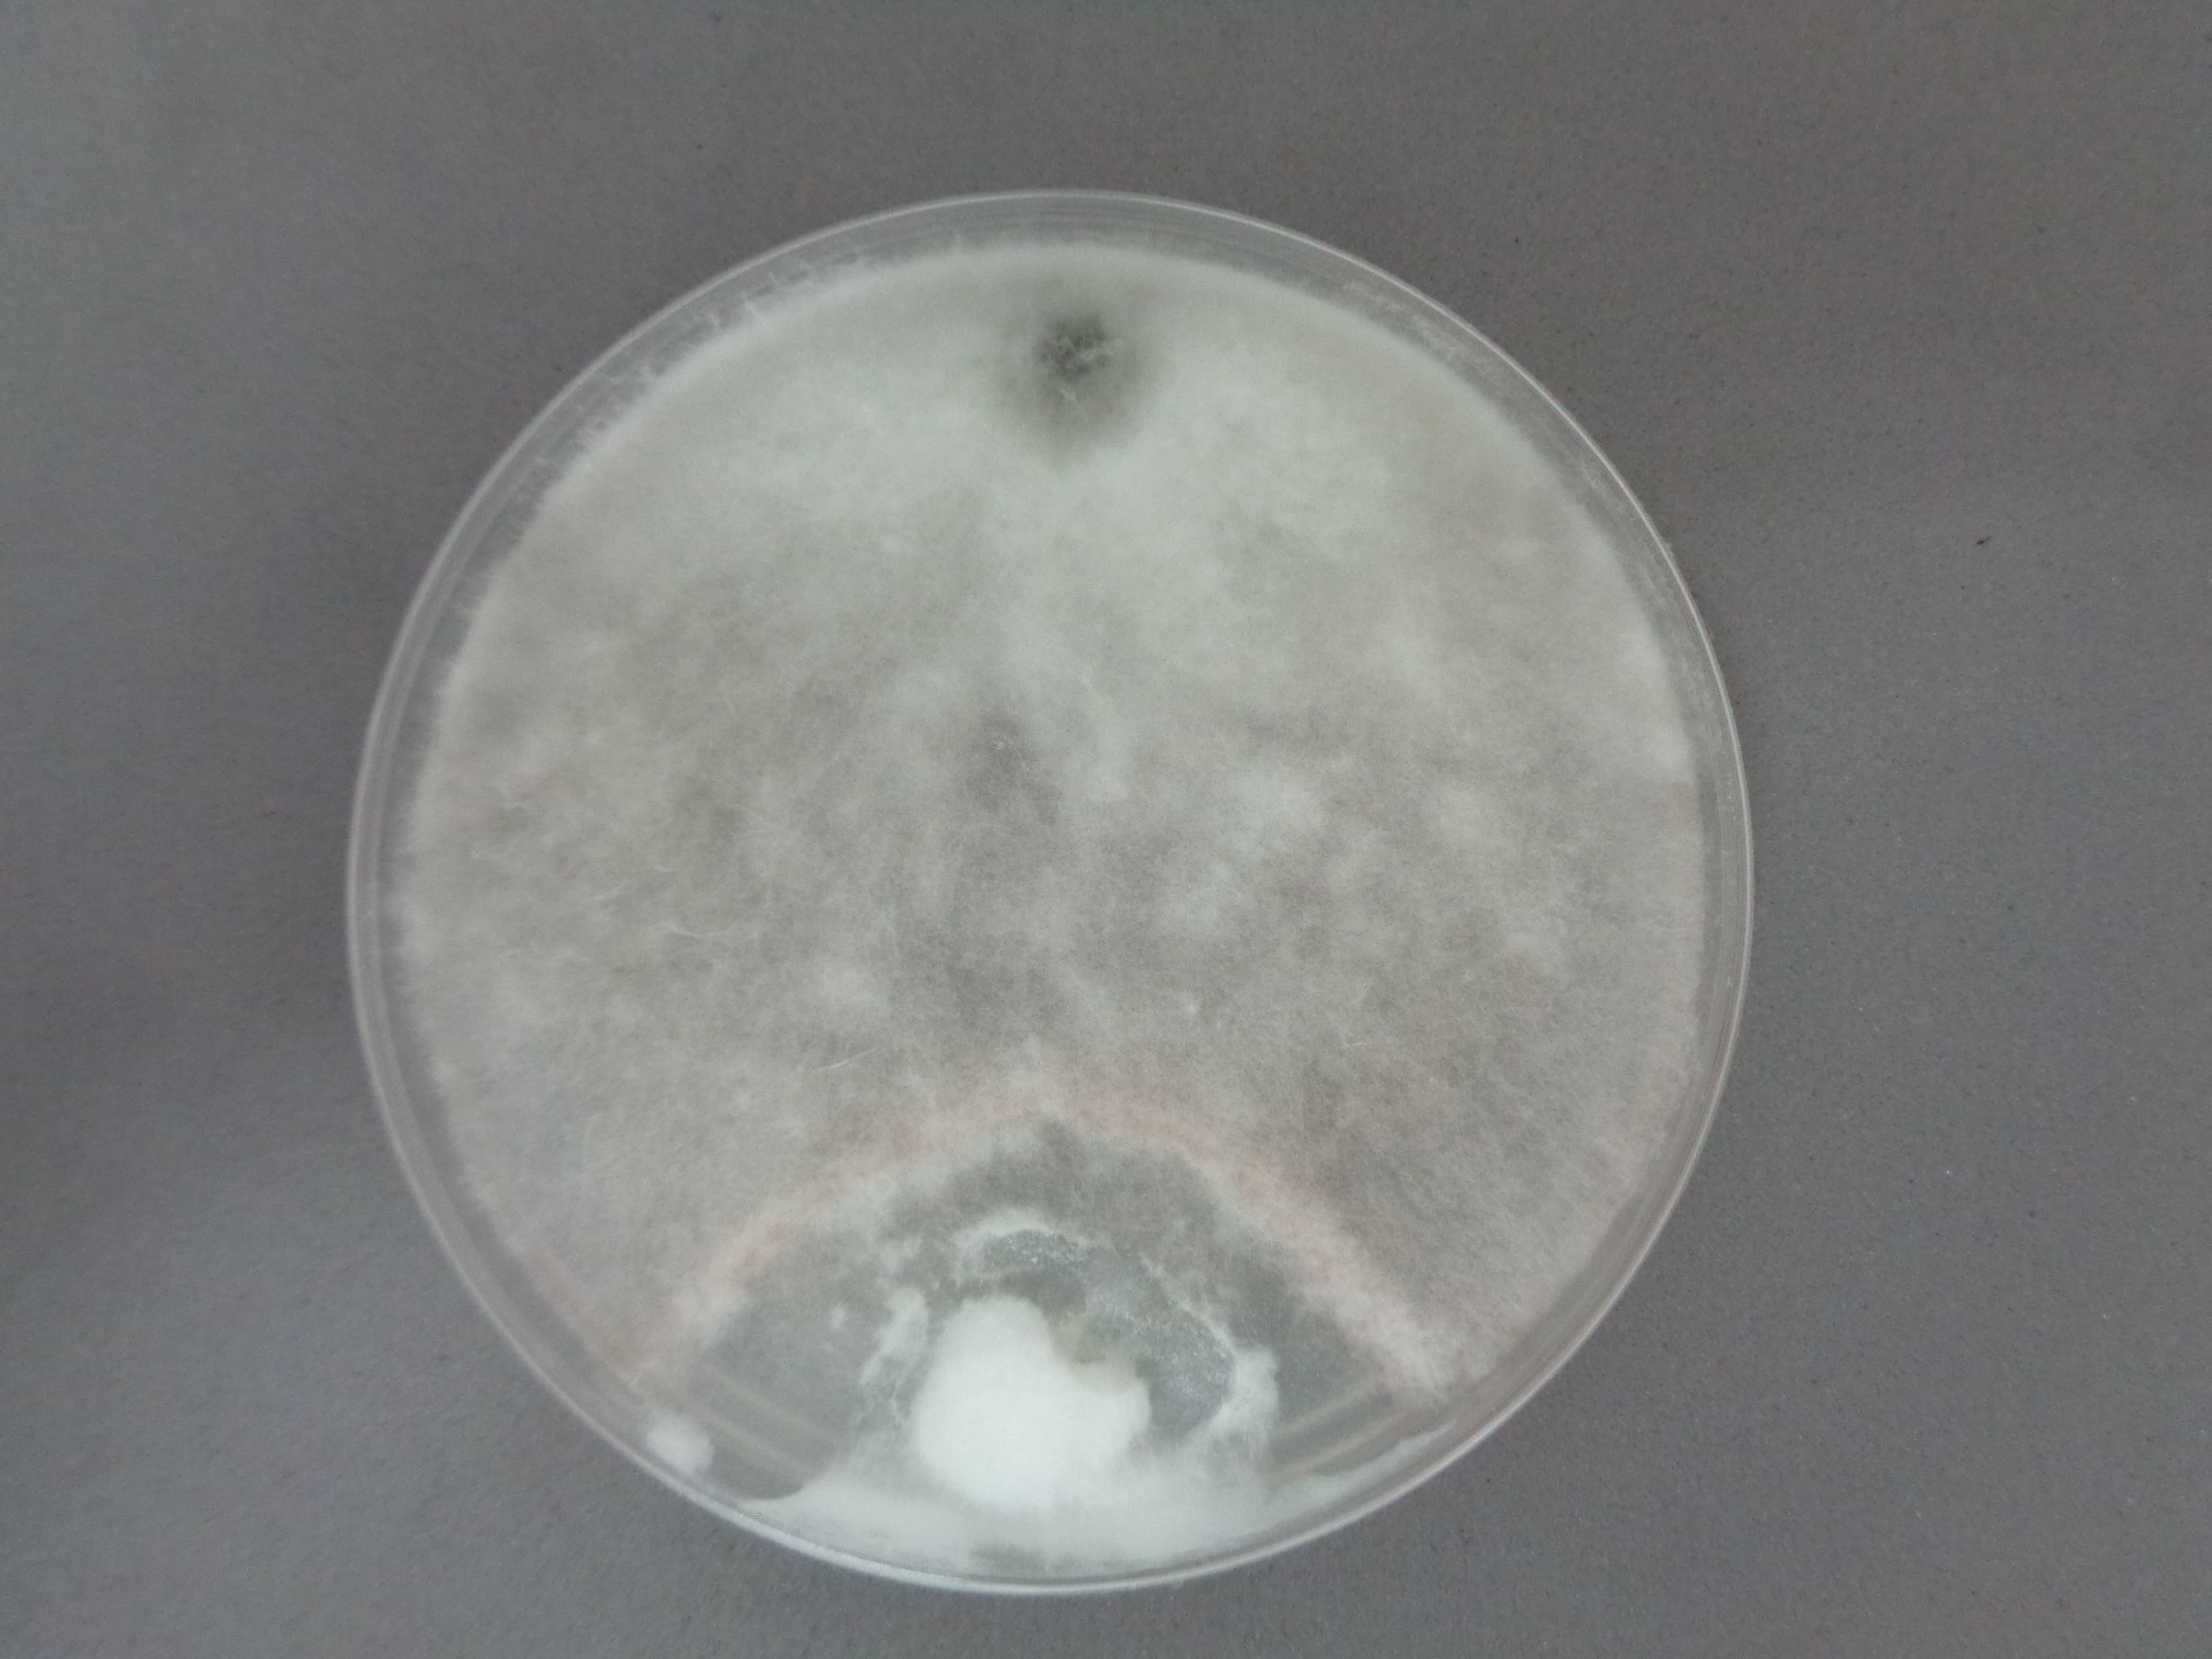
Trichoderma pigmentacion verde
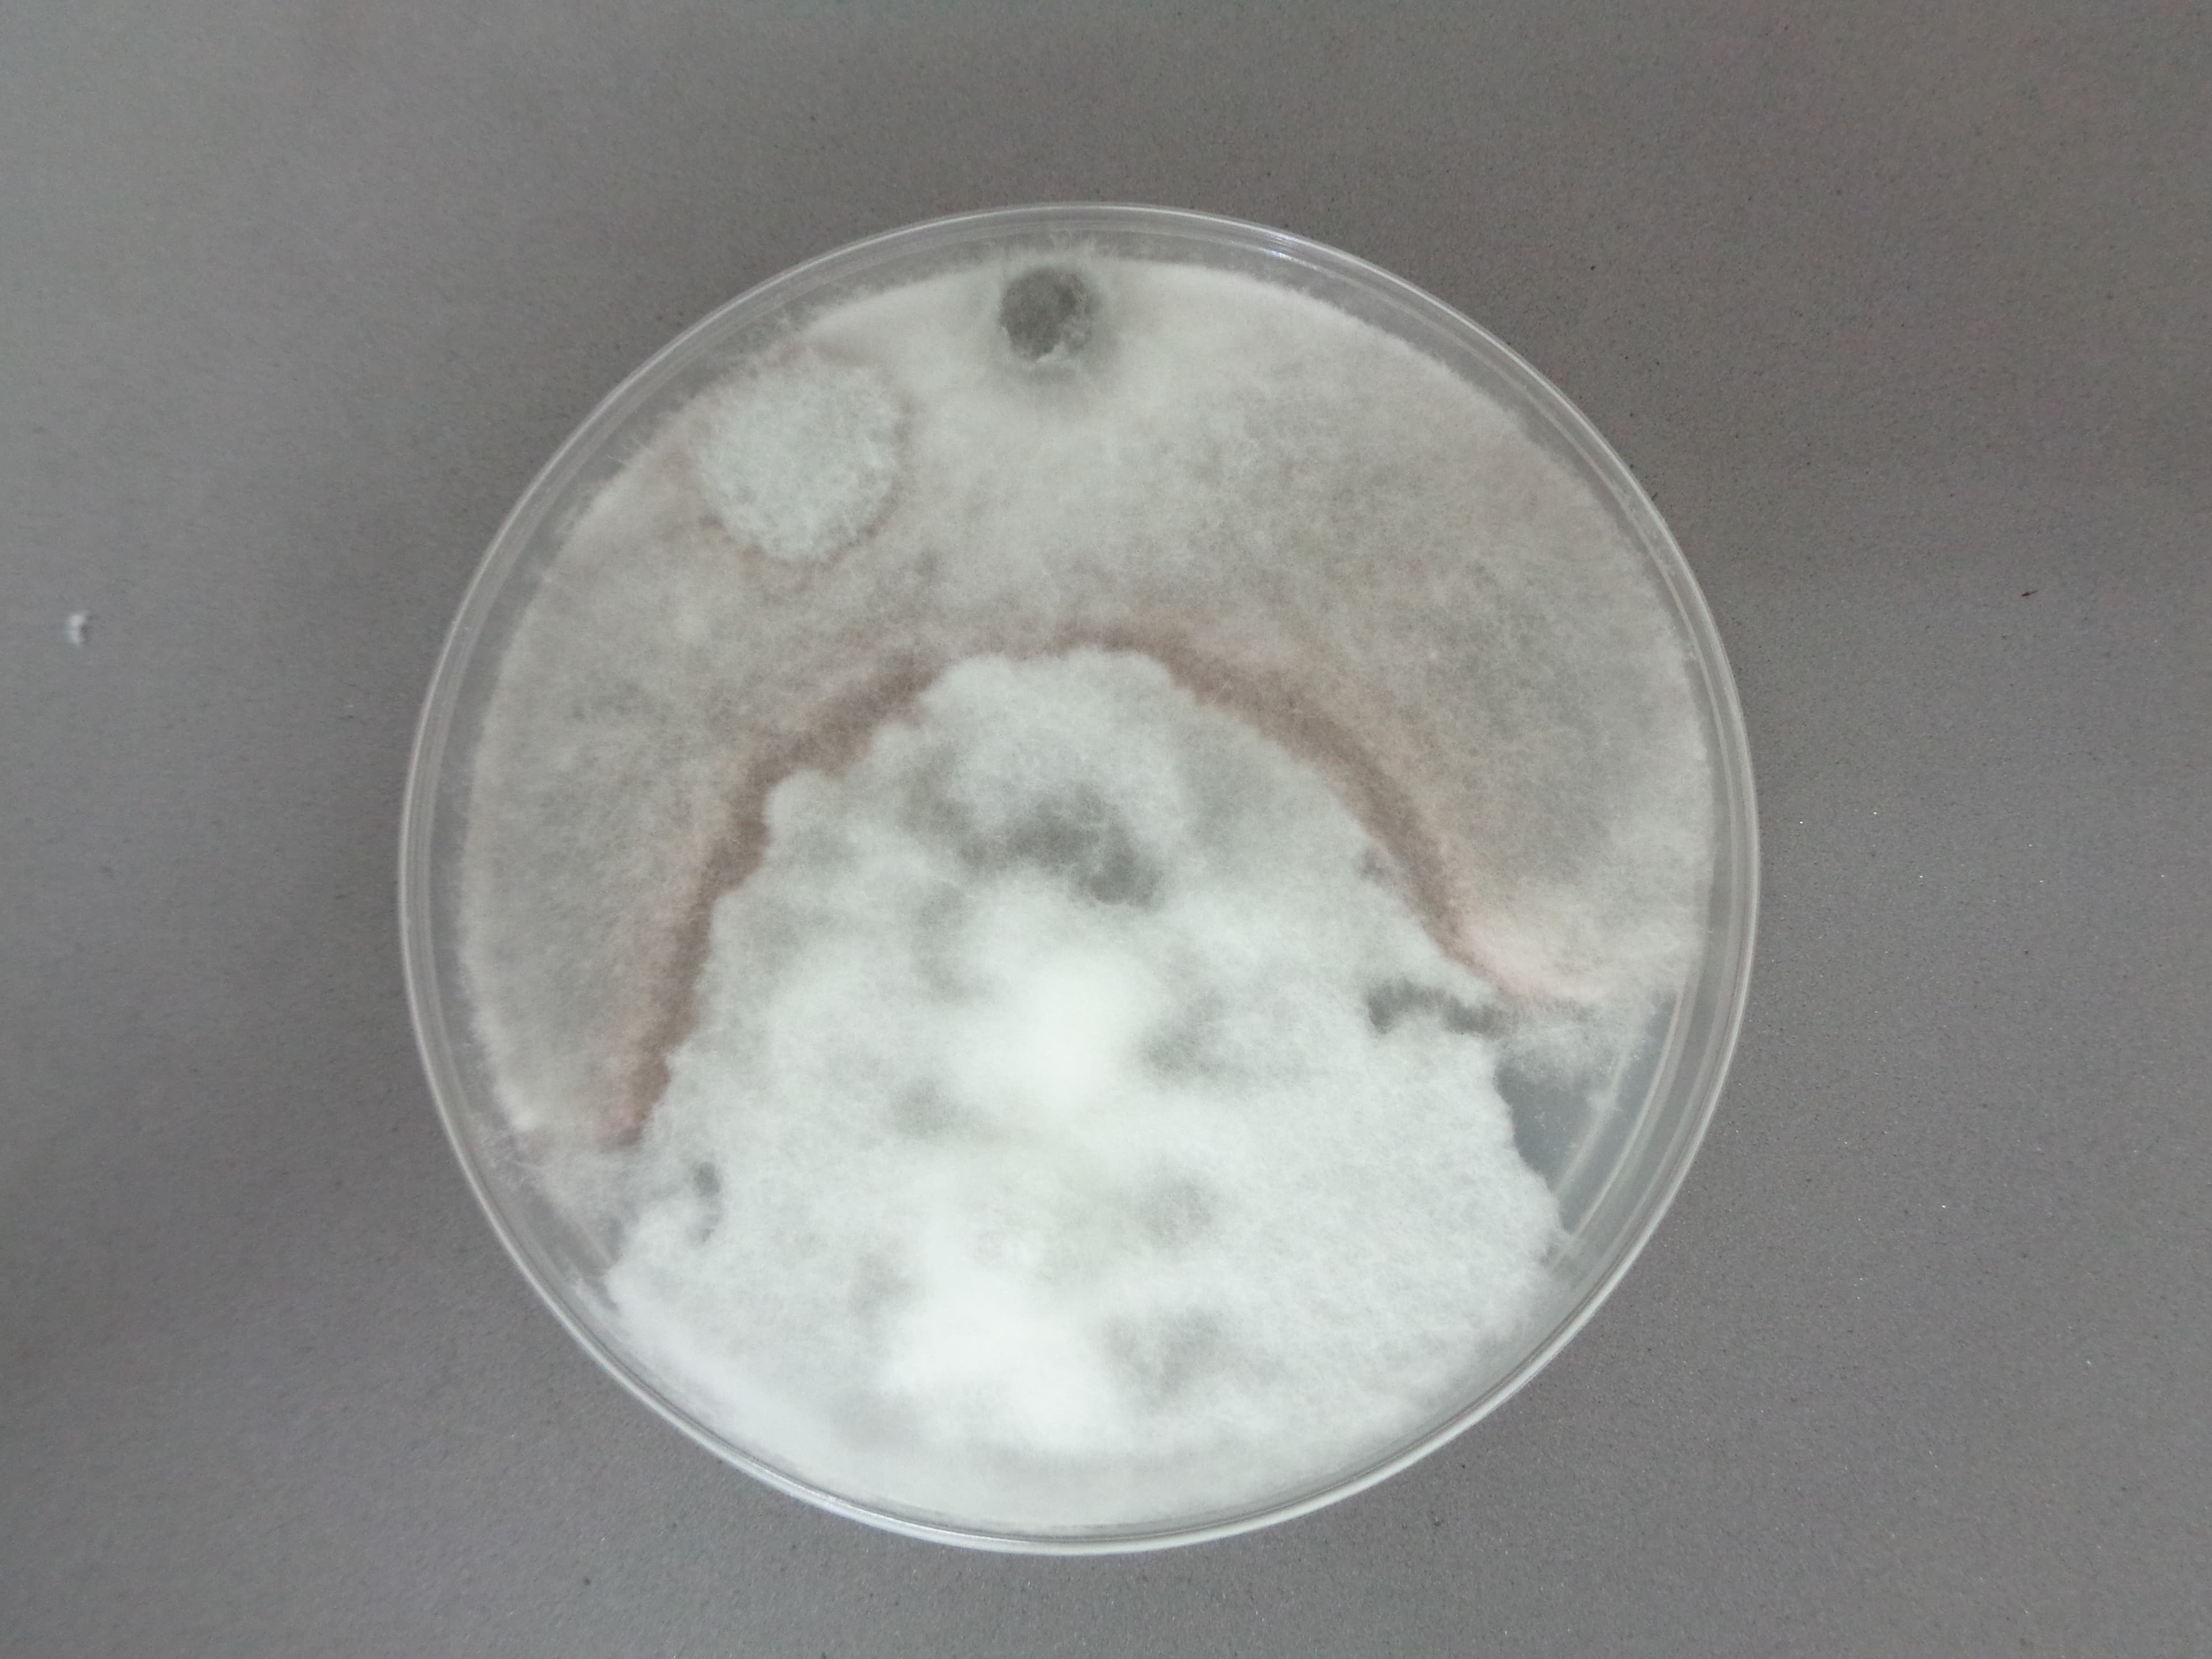
Trichoderma micelio aereo
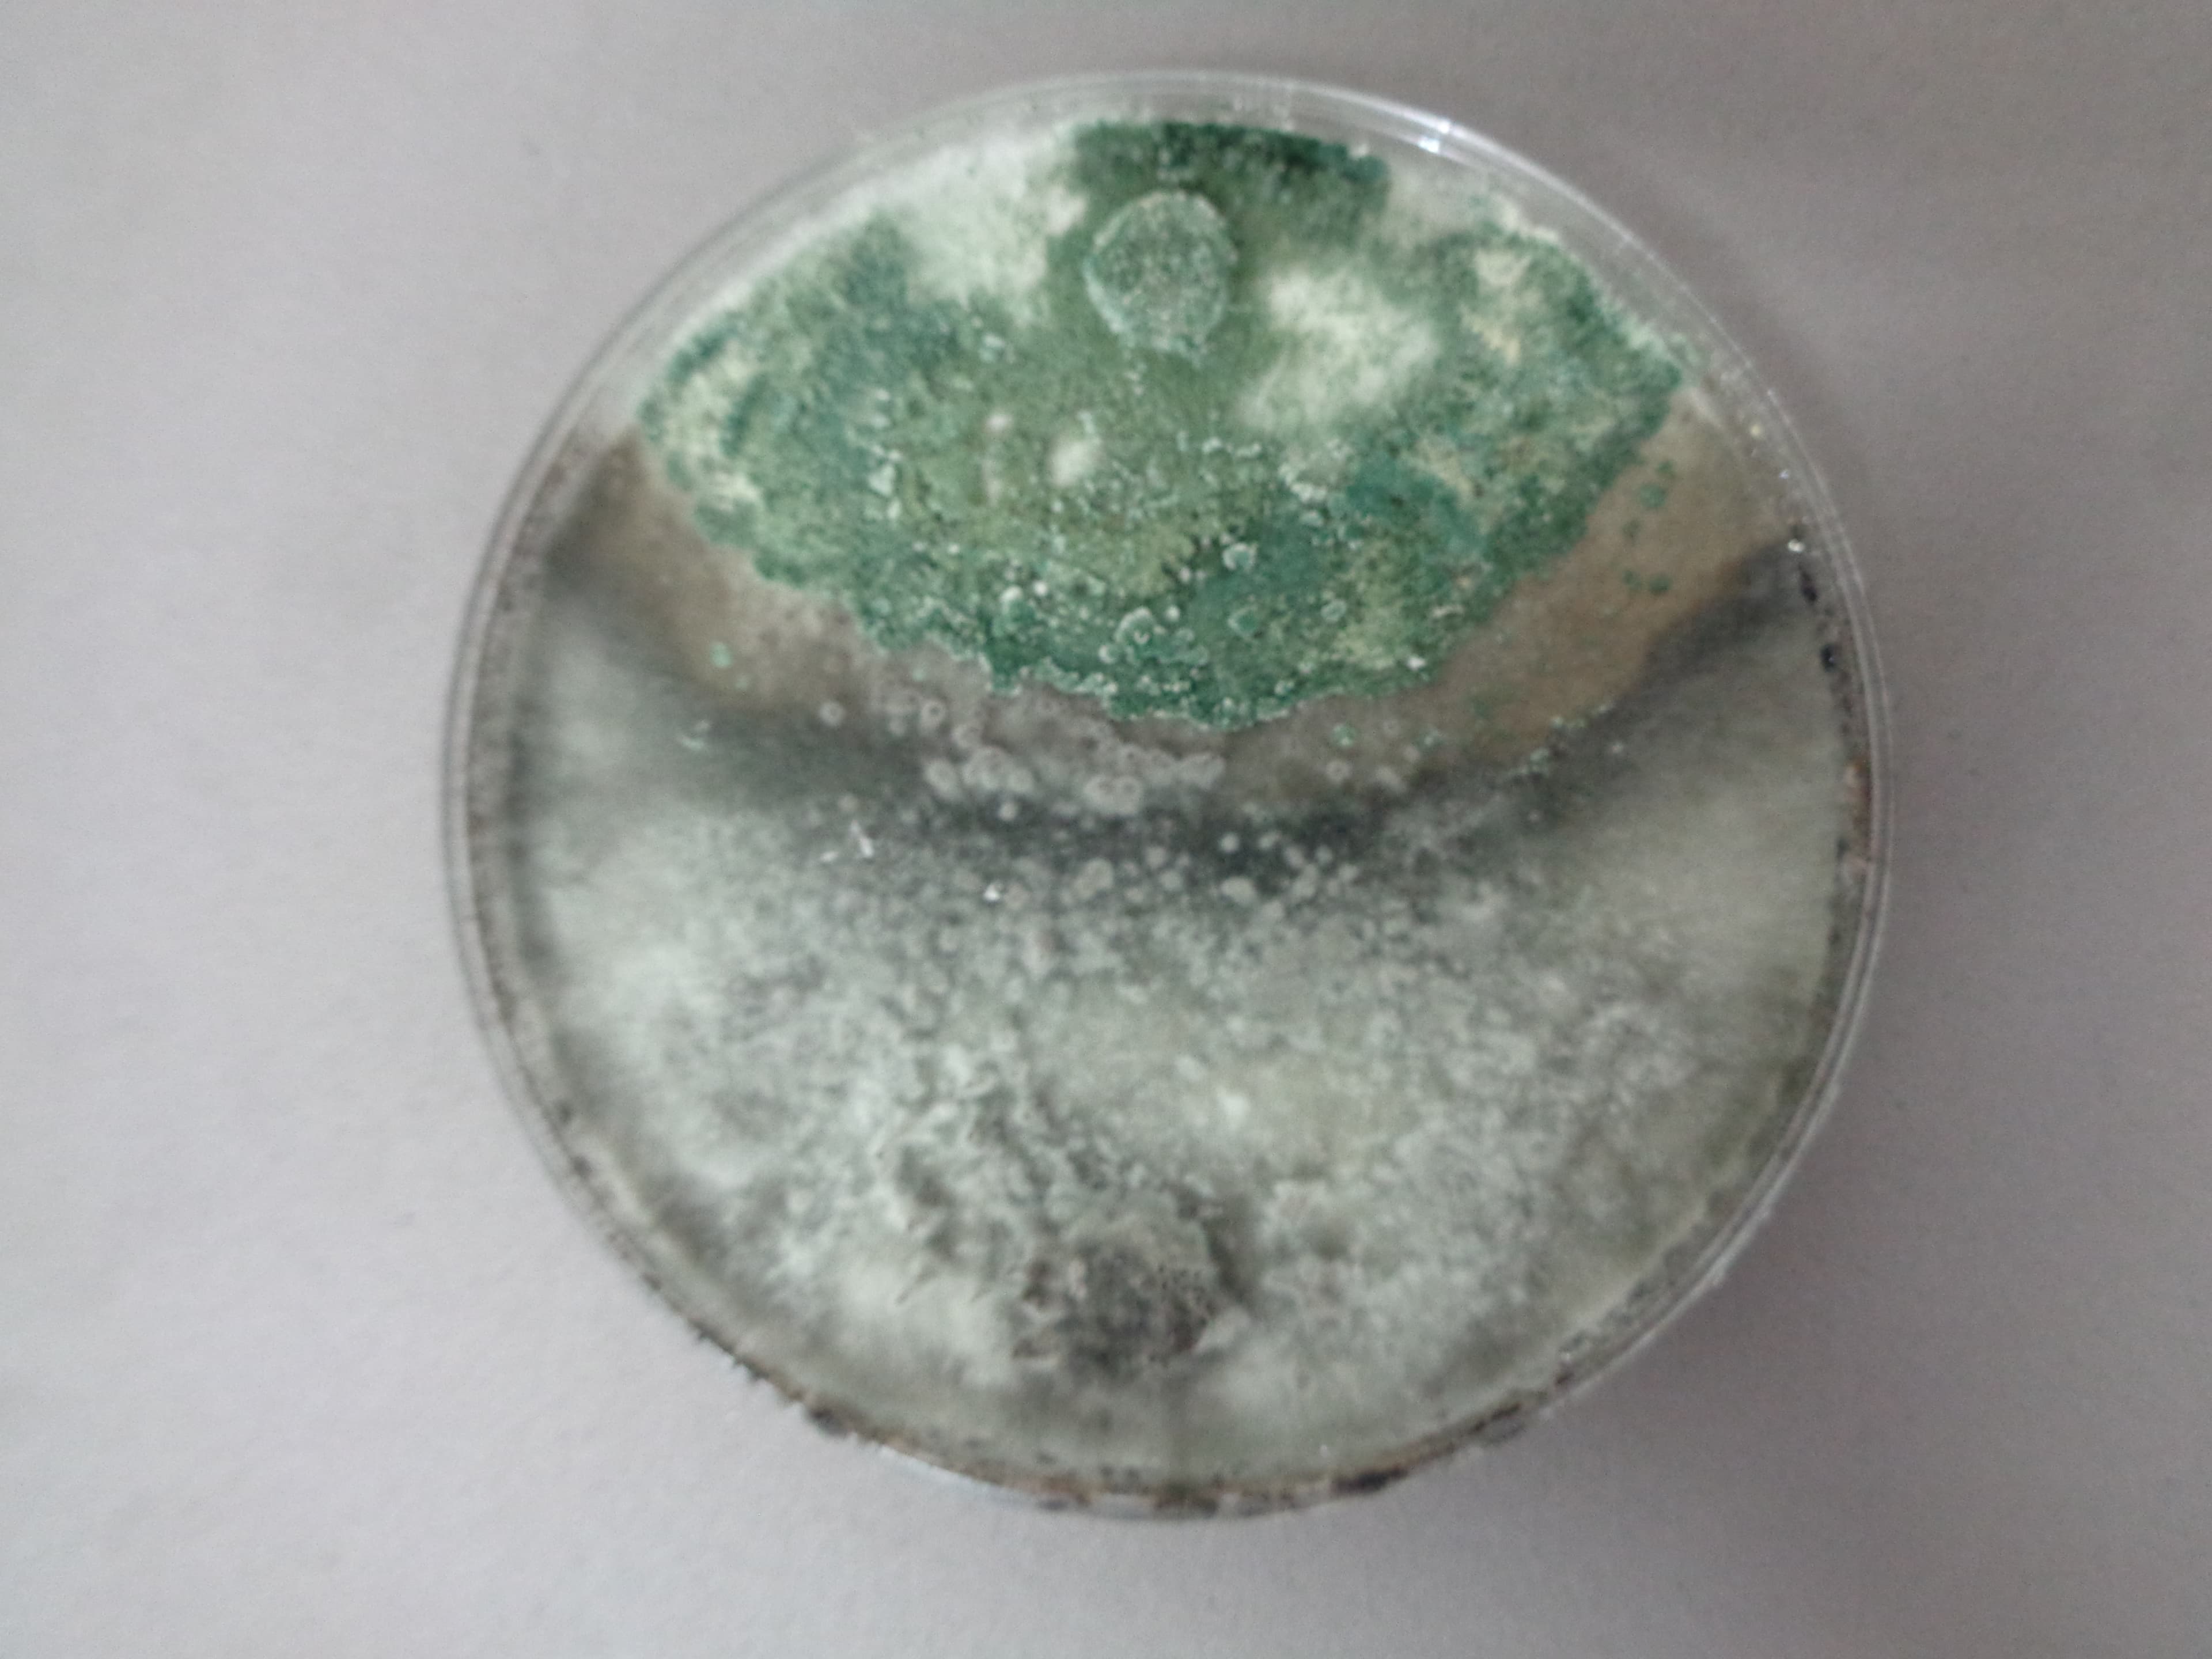
Esporulacion de Trichoderma
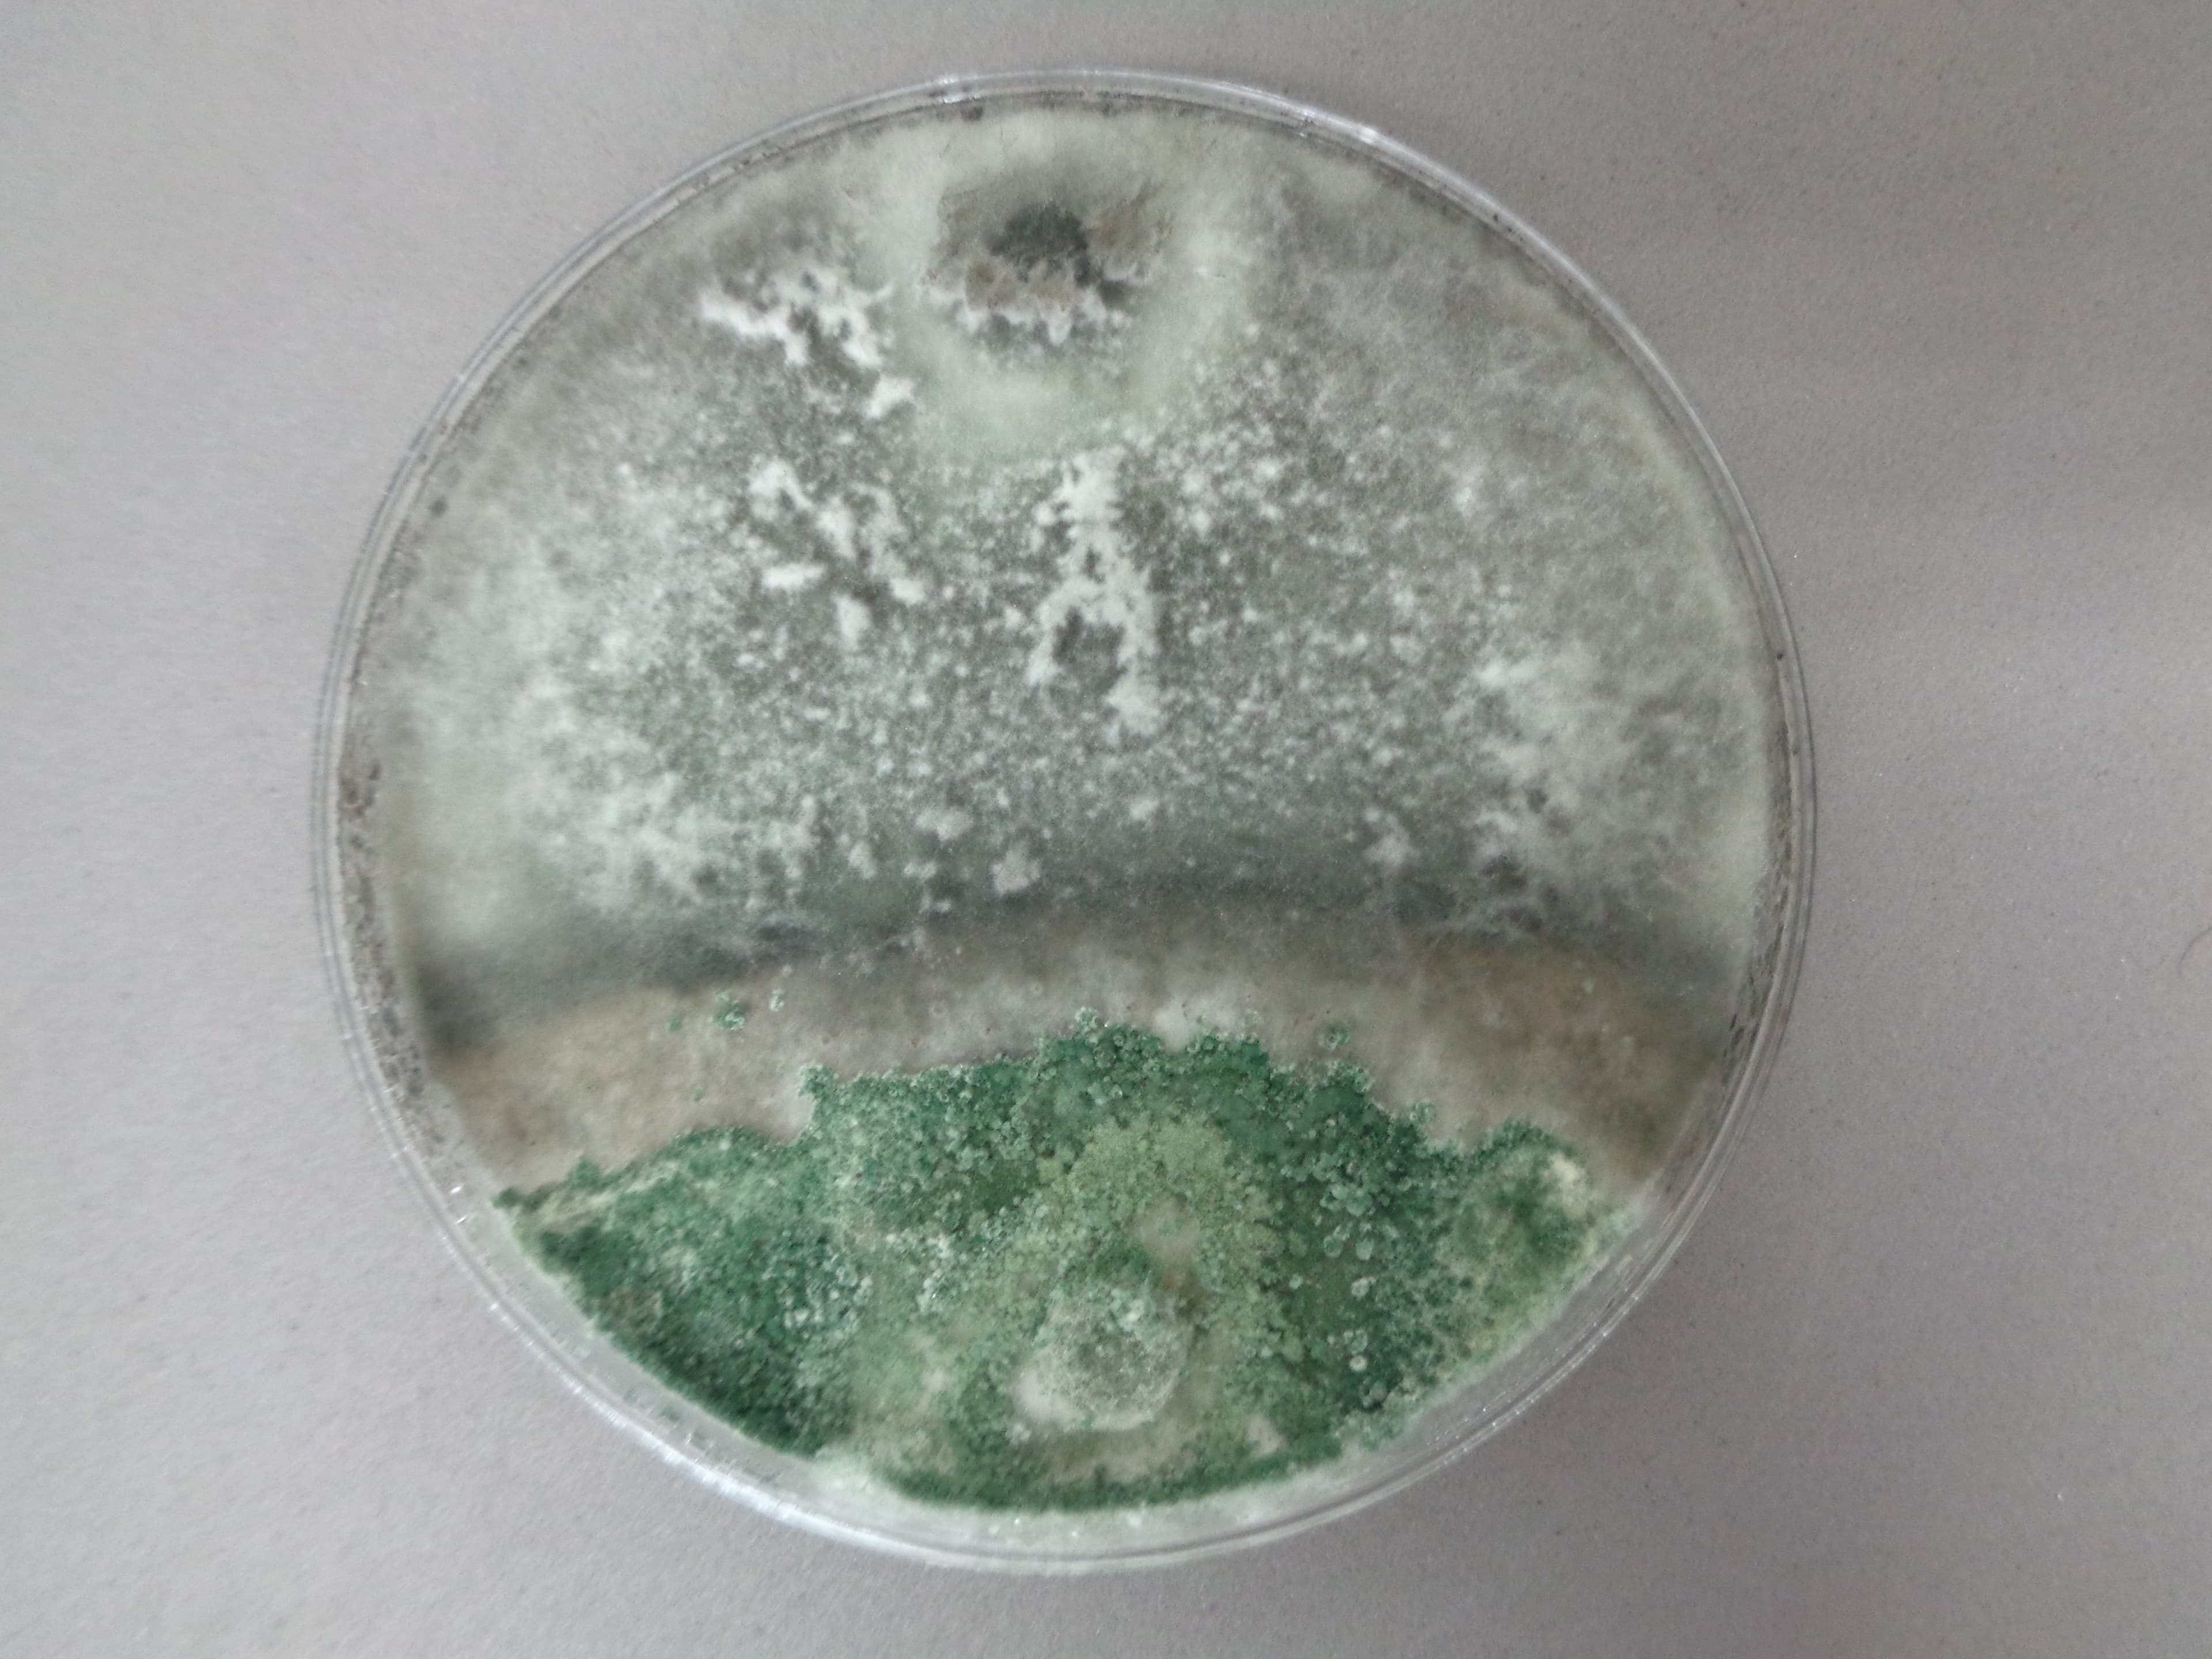
Colonia madura de Trichoderma
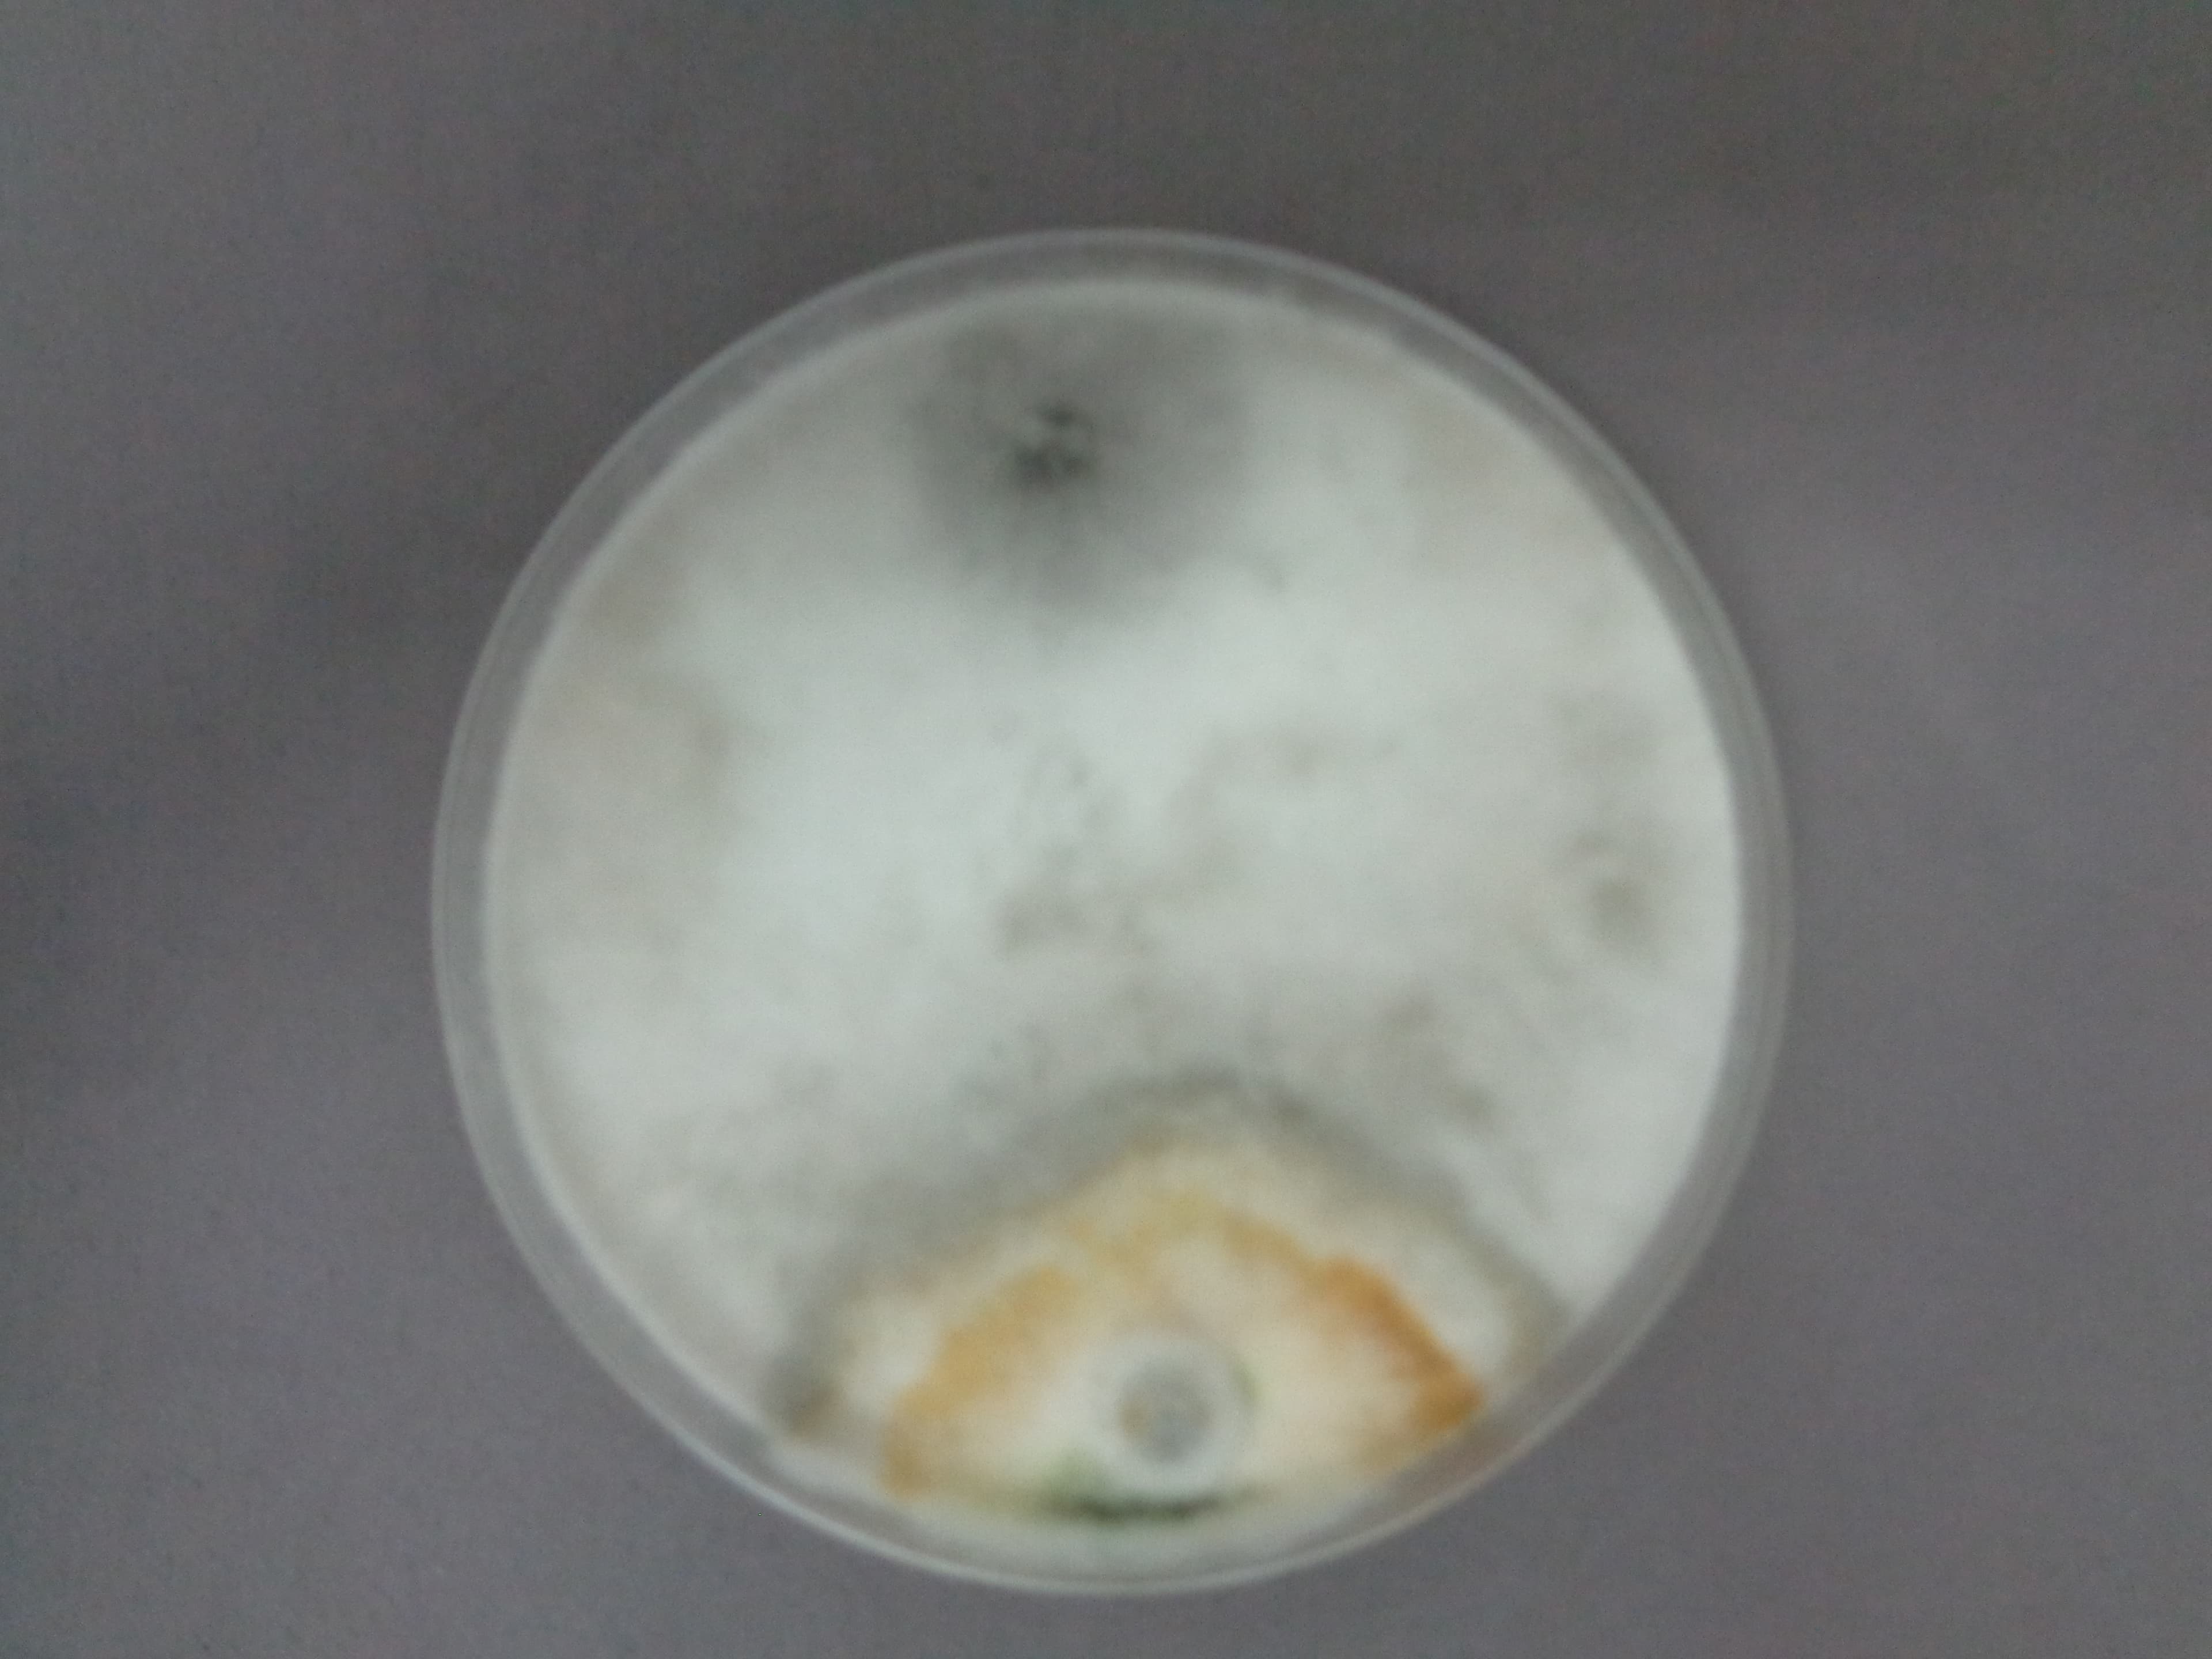
Trichoderma masas de esporas

Catalogo Morfologico
Galeria visual interactiva con microscopias, colonias y sintomatologia. Filtra por categoria y haz clic para ver detalles cientificos.
Colonia en PDA (Dia 1)
Trichoderma spp.BiocontrolEsporulacion inicial
Trichoderma spp.BiocontrolColonia madura
Trichoderma spp.BiocontrolDetalle de esporulacion
Trichoderma spp.BiocontrolCrecimiento radial
Trichoderma spp.BiocontrolPigmentacion verde
Trichoderma spp.BiocontrolMicelio aereo
Trichoderma spp.BiocontrolConidioforos
Trichoderma spp.BiocontrolPlaca completa
Trichoderma spp.BiocontrolMasas de esporas
Trichoderma spp.Biocontrol
Microscopia
Colletotrichum spp.Patogeno
Antracnosis en hojas
Passiflora edulisSintomatologiaLesiones en fruto
Colletotrichum spp.SintomatologiaManchas necroticas
Colletotrichum spp.SintomatologiaInfeccion avanzada
Colletotrichum spp.SintomatologiaDecaimiento de fruto
Colletotrichum spp.SintomatologiaEsporulacion en fruto
Colletotrichum spp.SintomatologiaDano severo
Colletotrichum spp.Sintomatologia
Chile Manzano
Capsicum pubescensHospederoMostrando 19 imagenes · Fotografia: Santo Angel OA